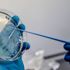
Avrupa'da 4 ülkeden Kovid-19 aşısı için ittifak

MORE IN DÜNYA»

Trump, siyahi Amerikalıların talebi üzerine Oklahoma mitingini b…
13 Haziran 2020 07:48
Kuzey Kore'den Güney Kore'ye uyarı, ABD'ye gözdağı: Gücümüzü gel…
13 Haziran 2020 13:49
Pekin'de Kovid-19 nedeniyle bir pazarın kapatılması sonrası 46 k…
13 Haziran 2020 21:48
Fransa’da ırkçılık karşıtı gösteriler devam ediyor
13 Haziran 2020 18:55
Amerika'da 174 yıllık geleneği bir Türk bozdu
13 Haziran 2020 19:58
Kovid-19 salgınında iyileşenlerin sayısı dünya genelinde 4 milyo…
13 Haziran 2020 19:49
Arap ülkelerinde Kovid-19 kaynaklı can kaybı ve vaka sayısı arttı
13 Haziran 2020 18:55
Son dakika… Corona virüsünde son durum: Meksika’da rekor, Brezil…
13 Haziran 2020 08:48
Çin'de şiddetli yağışlar nedeniyle 5 kişi öldü
13 Haziran 2020 09:54
Rusya'da hafif motorlu uçağın düşmesi sonucu 2 kişi öldü
13 Haziran 2020 13:49
Salgının başladığı Vuhan'da karantinadaki genç 102 kilo aldı
13 Haziran 2020 10:54
Çin'de yemek için kafeslerde tutulan 700 kedi kurtarıldı
13 Haziran 2020 12:50
Son dakika: Libya'daki toplu mezarlarlar Hafter vahşetini ortaya…
13 Haziran 2020 11:58
Darbeci Hafter kaçacak delik arıyor!
13 Haziran 2020 09:47
ABD’de protestolar nedeniyle ikinci dalga paniği
13 Haziran 2020 11:02
Prof. Dr. Ceyhan ‘Salgının mevsimi olmaz’ dedi ve uyardı: Sıcak …
13 Haziran 2020 10:56
Trump'tan tepki çeken LGBT kararı
13 Haziran 2020 02:50
ABD filosu, 3 yıl sonra Çin'e karşı Hint Pasifiği'nde
13 Haziran 2020 03:46
Türkiye'ye hakaret halkı sokağa döktü
13 Haziran 2020 07:00 resimsizBAE'nin Black Shied şirketi Sudanlı gençleri Hafter için Libya'y…
13 Haziran 2020 21:56
Fransa karıştı! Gözaltılar var
13 Haziran 2020 21:51
İsrail'de Başbakanlık konutunda görevli 3 koruma Kovid-19'a yaka…
13 Haziran 2020 21:48
Salgının yeni merkezinden korkutan haberler: Eski mezarlıkları k…
13 Haziran 2020 20:54
İngiltere'de polisten eylemcilere orantısız şiddet
13 Haziran 2020 20:51
Trablus'ta tuzaklanan mayınlar bir kadını öldürdü, oğlunu yarala…
13 Haziran 2020 20:47
Karadaği'den, BAE'ye "tutuklu alimleri serbest bırak" çağrısı
13 Haziran 2020 20:47
Rusya'da Covid-19 vakası sayısı 520 bini geçti
13 Haziran 2020 12:59
İspanya'da Covid-19'dan son bir haftada 27 kişi öldü
13 Haziran 2020 19:54
Avrupa'da 4 ülkeden Kovid-19 aşısı için ittifak
13 Haziran 2020 19:49 resimsizİsrail ordusu 4 Filistin vatandaşını vurdu
13 Haziran 2020 19:48
Azerbaycan'da son 24 saatte 352 yeni vaka
13 Haziran 2020 19:45
Başbakan savcıya 3 saat ifade verdi
13 Haziran 2020 18:45
Husilerden Suudi Arabistan'a balistik füze saldırısı! Havada imh…
13 Haziran 2020 17:50
Hafter yanlısı Tobruk Temsilciler Meclisi Başkanı Salih'den Ceza…
13 Haziran 2020 17:50
Güç dengesi değişebilir
13 Haziran 2020 17:50 resimsizİsveç Dışişleri Bakanı Linde'den skandal hareket: Terör örgütü P…
13 Haziran 2020 17:47
Güney Kıbrıs Rum Kesimi'nde koronadan sonra AIDS alarmı
13 Haziran 2020 17:46
Afganistan'da cami imamı silahlı saldırıda hayatını kaybetti
13 Haziran 2020 16:56
Almanya'da siyahi kadına kasiyer ve polisin ırkçı tavrı tartışma…
13 Haziran 2020 16:56
Rusya'da nisandaki Kovid-19 ölü sayısı önceki açıklanandan daha …
13 Haziran 2020 16:56 resimsizJaponya’daki intihar ormanında gezintiye çıkan Türkler şoka girdi
13 Haziran 2020 16:52
Yunanistan'da 'kezzap' olayının ardından kıskançlık çıktı
13 Haziran 2020 16:47
Washington'da ırkçılık karşıtı sessiz protesto
13 Haziran 2020 16:47
Ukrayna Başbakan Yardımcısı koronavirüse yakalandığını duyurdu
13 Haziran 2020 15:48
Afganistan'da Taliban saldırılarında 9 polis öldü
13 Haziran 2020 15:48
Çin'de Avustralyalı uyuşturucu kaçakçısı idama mahkum edildi
13 Haziran 2020 15:48
Eski Yunan istihbaratçı Kalenderisis'ten itiraf gibi sözler: Tür…
13 Haziran 2020 15:48
Uluslararası Af Örgütü, Hırvat polisinin sığınmacılara yönelik i…
13 Haziran 2020 15:48
Hint komutandan Çin-Hindistan sınırındaki durumun kontrol altınd…
13 Haziran 2020 14:50
Yemen'de hükümet güçleriyle BAE destekli silahlı gruplar arasınd…
13 Haziran 2020 14:50
Fransa'da stratejik balistik füze denemesi
13 Haziran 2020 14:50
İran'da Covid-19 nedeniyle ölenlerin sayısı 8 bin 730'a yükseldi
13 Haziran 2020 13:57
Ortalığı daha da kızıştıracak ölüm: Siyahi genç ağaçta asılı bul…
13 Haziran 2020 13:49
Fransa Avrupa içi sınırlarını 15 Haziran'da açacak
13 Haziran 2020 13:49
Belçika'da koronavirüs vakası sayısı 60 bine yaklaştı
13 Haziran 2020 13:49
İran Afganistan'ın Tahran Büyükelçisini Dışişleri Bakanlığına ça…
13 Haziran 2020 12:51
Polonya sınırlarını yabancılara açıyor
13 Haziran 2020 12:51
Başbakan Boris Johnson ve Churcill'in torunu ateş püskürdü: Tari…
13 Haziran 2020 12:51
Suriye Lirası’ndaki kriz ve İdlib’de dram
13 Haziran 2020 12:50
Rusya'da koronavirüs vaka sayısı 520 bini geçti
13 Haziran 2020 12:50HOTTEST NEWS IN DÜNYA»
WHAT'S NEW IN DÜNYA»
- Eyvah eyvah durum bu sefer ciddi! Dev astero…
- NATO Genel Sekreteri Stoltenberg'den Rusya'y…
- İran Cumhurbaşkanı Reisi ile Rusya Devlet Ba…
- Rusya kendini yalanladı! Uzay aracı nasıl dü…
- Fransa'yı etkisi altına alan akım: Daltonlar
- Avrupa'da gaz fiyatları yükselişe geçti! Alm…
- Azerbaycan: Ermenistan'la gerginlik sürüyor
- Jens Stoltenberg: Rusya'nın uydu vurması per…
- Kardeş ülke harekete geçti: Düşmanın saldırı…
- İsrail güçleri tarafından vurulan Filistinli…
- Facebook’ta tanıştığı ABD’li gençle, Zoom’da…
- Polonya-Belarus sınırında gerilim: Tazyikli …
- Koronavirüs hapında flaş gelişme! Pfizer lis…
- Konut fiyatlarında ilk gerçekleşti
- Dolar: TL'nin bugünkü değer kaybını ekonomis…
- Sıfır otomobilde fiyat oyunu
- İş Bankası Genel Müdürü'nden Erdoğan'ı kız…
- Atilla Yeşilada İktidarı 90’lı yıllardan ve…
- Getir ünlü alışveriş sitesine ortak oluyor.…
- Kuzey Kore lideri Kim Jong'dan akılalmaz pro…


